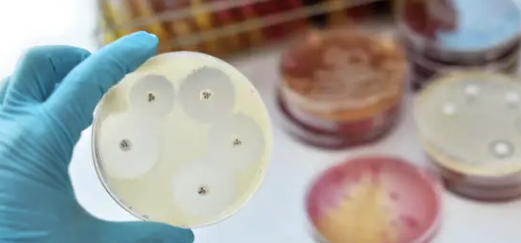
수두 증상 27

목차

수두는 **수두-대상포진 바이러스(Varicella-zoster virus)**에 의해 발생하는 전염성 높은 바이러스성 질환입니다.
주로 어린이에게 많이 나타나지만, 어른도 걸릴 수 있죠.
수두는 매우 전염성이 강해서 감염된 사람과 가까이 있거나, 같은 공간에 있는 것만으로도 쉽게 전염될 수 있습니다.
수두 바이러스가 공기 중에 퍼지거나, 발진을 통한 바이러스의 직접 접촉을 통해 전염됩니다.😢
수두를 예방하기 위해서는 백신 접종이 가장 좋은 방법입니다.
아래에서 수두 증상 10가지 총정리에 대한 내용을 알아보겠습니다.
수두 증상 10가지 총정리


수두는 바리셀라-조스터 바이러스에 의해 발생하는 전염성이 높은 질환으로, 주로 어린이에게서 경미한 증상으로 나타납니다.
수두의 주요 증상은 다음과 같습니다.
| 수두 증상 | 설명 |
| 발진 | 작은 붉은 반점이 얼굴과 두피에서 시작해 몸과 팔다리로 퍼짐. 물집으로 변하고 딱지로 변함. |
| 가려움증 | 발진과 함께 심한 가려움증을 동반함. |
| 발열 | 경미한 발열이 초기 증상으로 나타날 수 있음. |
| 두통 | 수두의 일반적인 증상 중 하나. |
| 피로감 | 감염 초기에는 피로감을 느낄 수 있음. |
| 근육통 | 일부 환자에게서 나타날 수 있는 증상. |
| 식욕 부진 | 수두에 걸리면 식욕이 떨어질 수 있음. |
| 전신 통증 | 발열과 함께 전신에 통증이 있을 수 있음. |
| 잠복기 | 10~21일의 잠복기를 가지며, 이 기간 동안 증상이 나타나지 않을 수 있음. |
| 합병증 가능성 | 드물게 폐렴, 뇌염, 피부 감염 등의 합병증을 일으킬 수 있음. 주로 면역력이 약한 사람에게 발생. |
아래에서 수두의 증상에 대해 자세하게 알려드리겠습니다.
1. 발진



수두의 가장 특징적인 증상은 발진입니다.
처음에는 작은 붉은 반점이 얼굴과 두피에서 시작되며, 빠르게 몸과 팔다리로 퍼집니다. 이 반점들은 시간이 지나면서 물집으로 변하고, 이후 딱지로 변하게 됩니다. 발진은 수두의 초기부터 나타나는 주요 증상 중 하나로, 점차적으로 전신에 퍼지게 됩니다.
왼쪽 아랫배 통증 12가지 총정리
왼쪽 아랫배 통증은 여러 가지 원인에 의해 발생할 수 있고, 가벼운 근육통부터 시작해서 장기 문제나 염증 같은 더 심각한 원인까지 다양합니다.왼쪽 아랫배에 통증이 있을 때는, 통증의 원인
satporobeer.com
2. 가려움증



수두 발진은 심한 가려움증을 동반해요. 이 가려움증은 매우 불편하며, 발진 부위를 긁고 싶어질 수 있지만, 긁으면 피부에 상처가 생기거나 감염될 수 있기 때문에 주의가 필요합니다. 가려움증은 수두를 앓는 동안 지속될 수 있는 주요 증상 중 하나입니다.
3. 발열



수두에 걸리면 경미한 발열이 초기 증상으로 나타날 수 있어요. 이 발열은 체온이 살짝 오르는 정도로 시작되며, 발진이 나타나기 전이나 발진과 함께 발생할 수 있습니다. 발열은 수두가 진행되는 동안 종종 동반되는 증상입니다.
땀띠 가라앉히는 방법 10가지 총정리
땀띠는 피부에 땀이 많이 나서 생기는 작은 발진입니다. 주로 여름처럼 덥고 습한 날씨에 많이 생기며, 특히 피부가 접히거나 옷으로 덮여있는 부분에서 자주 발생하죠.땀이 피부 밖으로 잘 나
satporobeer.com
4. 두통



두통은 수두의 일반적인 증상 중 하나입니다. 감염 초기나 발진이 나타나기 전에 나타날 수 있으며, 가벼운 두통부터 심한 두통까지 다양할 수 있습니다. 두통은 발열과 함께 나타나는 경우가 많습니다.
5. 피로감



수두에 걸리면 몸이 피로하고 기운이 없는 느낌을 받을 수 있어요. 이 피로감은 감염 초기부터 시작될 수 있으며, 몸이 수두 바이러스와 싸우기 위해 에너지를 소모하기 때문에 발생하는 증상입니다.
6. 근육통



일부 수두 환자에게는 근육통이 나타날 수 있습니다. 특히 발열과 함께 전신의 근육이 아프고 뻐근한 느낌이 들 수 있습니다. 근육통은 수두 바이러스가 몸 전체에 영향을 미치면서 발생할 수 있는 증상입니다.
7. 식욕 부진



수두에 걸리면 식욕이 떨어질 수 있어요. 몸이 아프고 기운이 없어서 음식을 먹고 싶지 않을 수 있으며, 이는 수두에 걸린 동안 흔히 나타나는 증상 중 하나입니다.
8. 전신 통증



수두 환자는 발열과 함께 전신에 통증을 느낄 수 있습니다. 몸 전체가 아프고 피로한 느낌이 들며, 이는 수두가 전신에 영향을 미치기 때문에 발생하는 증상입니다.
9. 잠복기

수두는 감염 후 약 10~21일의 잠복기를 가집니다. 이 기간 동안에는 증상이 나타나지 않기 때문에 수두에 걸렸다는 것을 알기 어렵습니다. 하지만 잠복기가 끝나면 발진과 발열 등의 증상이 나타나기 시작합니다.
10. 합병증 가능성



드물지만, 수두는 폐렴, 뇌염, 또는 피부 감염과 같은 합병증을 일으킬 수 있습니다. 특히 면역력이 약한 사람들에게서 이러한 합병증이 발생할 가능성이 더 높습니다.
합병증이 발생하면 증상이 심각해질 수 있으므로, 수두 증상이 심하거나 면역력이 약한 사람들은 특히 주의가 필요합니다.
수두는 매우 전염성이 강하므로, 감염된 사람과의 접촉을 피하고 예방 접종을 통해 감염을 예방하는 것이 중요합니다.
마무리
오늘은 수두 증상 10가지 총정리에 대해 알아보았습니다.
'건강' 카테고리의 다른 글
| 감기 증상 10가지 총정리 (0) | 2024.08.23 |
|---|---|
| 담적병 증상 13가지 총정리 (0) | 2024.08.22 |
| 왼쪽 아랫배 통증 12가지 총정리 (0) | 2024.08.21 |
| 땀띠 가라앉히는 방법 10가지 총정리 (0) | 2024.08.21 |
| 오른쪽 옆구리 통증 의심되는병 12가지 총정리 (0) | 2024.08.20 |
